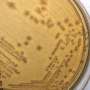

Dear Reader ,
Here is your customized Science X Newsletter for July 1, 2016:
Spotlight Stories Headlines
Astronomy & Space news
 | Curiosity rover's sand-dune studies yield surpriseSome of the wind-sculpted sand ripples on Mars are a type not seen on Earth, and their relationship to the thin Martian atmosphere today provides new clues about the atmosphere's history. |
 | NASA's Juno spacecraft enters Jupiter's magnetic fieldNASA's Jupiter-bound Juno spacecraft has entered the planet's magnetosphere, where the movement of particles in space is controlled by what's going on inside Jupiter. |
 | Gravitational lens zooms in on why some quasars have the radio turned downMini-jets of material ejected from a central supermassive black hole appear to be the culprits behind faint radio wave emissions in 'radio-quiet' quasars. A study of gravitationally lensed images of four radio-quiet quasars has revealed the structure of these distant galaxies in unprecedented detail. This has enabled astronomers to trace the radio emissions to a very small region at the heart of the quasars, and helped to solve a 50-year-old puzzle about their source. The results will be presented by Dr Neal Jackson at the National Astronomy Meeting in Nottingham on Friday, 1st July. |
 | Chance microlensing events probe galactic coresSome galaxies pump out vast amounts of energy from a very small volume of space, typically not much bigger than our own solar system. The cores of these galaxies, so called Active Galactic Nuclei or AGNs, are often hundreds of millions or even billions of light years away, so are difficult to study in any detail. Natural gravitational 'microlenses' can provide a way to probe these objects, and now a team of astronomers have seen hints of the extreme AGN brightness changes that hint at their presence. Leading the microlensing work, PhD student Alastair Bruce of the University of Edinburgh presents their work today (Friday 1 July) at the National Astronomy Meeting in Nottingham. |
 | Static electricity may transport dust across airless planetary bodiesA NASA-funded research team, led by Mihaly Horanyi at the University of Colorado-Boulder (CU-Bolder), has conducted laboratory experiments to bring closure to a long-standing issue of electrostatic dust transport, explaining a variety of unusual phenomena on the surfaces of airless planetary bodies, including observations from the Apollo era to the recent Rosetta comet mission. The research being done at the Institute for Modeling Plasma, Atmospheres and Cosmic Dust (IMPACT) was recently published in the journal Geophysical Research Letters, and explains how dust may be transporting across vast regions above the lunar surface and rings of Saturn, without winds or flowing water. |
 | ALMA discovers dew drops surrounding dusty spider's webAstronomers have spotted glowing droplets of condensed water in the distant Spiderweb Galaxy – but not where they expected to find them. Detections with the Atacama Large Millimeter/submillimeter Array (ALMA) show that the water is located far out in the galaxy and therefore cannot be associated with central, dusty, star-forming regions, as previously thought. The results will be presented at the National Astronomy Meeting 2016 in Nottingham by Dr Bitten Gullberg on Friday 1st July. |
 | Jupiter's mysteries to be revealed starting July 4On July 4, the veil over Jupiter's mysteries will be ripped away with the arrival of NASA's Juno mission, and Jonathan Lunine will be there to watch it happen. |
 | NASA's Juno and JEDI prepare to unlock the mysteries of JupiterOn board NASA's Juno spacecraft—which is set to enter Jupiter's orbit on July 4—are instruments that will help scientists answer fundamental questions about not just the solar system's largest planet, but also about Earth and the universe. |
 | New system discovered with five planetsNASA's planet-discovering Kepler mission suffered a major mechanical failure in May 2013, but thanks to innovative techniques subsequently implemented by astronomers the satellite continues to uncover worlds beyond our solar system (i.e., exoplanets). Indeed, Andrew Vanderburg (CfA) and colleagues just published results highlighting a new system found to host five transiting planets, which include: two sub-Neptune sized planets, a Neptune sized planet, a sub-Saturn sized planet, and a Jupiter sized planet. |
 | Juno spacecraft to kick into planned autopilot for July 4 Jupiter burnAt about 12:15 pm PDT today (3:15 p.m. EDT), mission controllers will transmit command product "ji4040" into deep space, to transition the solar-powered Juno spacecraft into autopilot. It will take nearly 48 minutes for the signal to cover the 534-million-mile (860-million-kilometer) distance between the Deep Space Network Antenna in Goldstone, California, to the Juno spacecraft. While sequence ji4040 is only one of four command products sent up to the spacecraft that day, it holds a special place in the hearts of the Juno mission team. |
 | AutoLens analysis steps up for Euclid's 100,000 strong gravitational lens challengeThe European Space Agency's Euclid satellite, due for launch in 2020, will set astronomers a huge challenge: to analyse one hundred thousand strong gravitational lenses. The gravitational deflection of light from distant astronomical sources by massive galaxies (strong lenses) along the light path can create multiple images of the source that are not just visually stunning, but are also valuable tools for probing our Universe. Now, in preparation for Euclid's challenge, researchers from the University of Nottingham have developed 'AutoLens', the first fully-automated analysis software for strong gravitational lenses. James Nightingale will present the first results from AutoLens at the National Astronomy Meeting 2016 in Nottingham on Friday, 1st July. |
 | Dawn completes primary missionOn June 30, just in time for the global celebration known as Asteroid Day, NASA's Dawn spacecraft completes its primary mission. The mission exceeded all expectations originally set for its exploration of protoplanet Vesta and dwarf planet Ceres. |
 | Infographic: Juno, built to withstand intense radiation environmentsJuno has been headed for Jupiter since 2011 to study the gas giant's atmosphere, aurora, gravity and magnetic field. This infographic illustrates the radiation environments Juno has traveled through on its journey near Earth and in interplanetary space. |
 | Australian researchers have developed ultra-accurate synchronisation tech for largest telescopeLast week, a team of Australian researchers successfully completed 'Astronomical Verification' of a critical sub-system of the Square Kilometre Array (SKA)—the forthcoming radio telescope that will be the largest and most sensitive on Earth. |
 | Image: Hubble hotbed of vigorous star formationThis NASA/ESA Hubble Space Telescope image reveals the iridescent interior of one of the most active galaxies in our local neighborhood—NGC 1569, a small galaxy located about eleven million light-years away in the constellation of Camelopardalis (The Giraffe). |
 | Unsolved mysteries about the solar system's biggest planetSwirling storms. Dusty rings. Glowing polar lights. |
 | Biological system reduces amount of freight for delivery to orbitEver wondered why humans have not colonized Mars, or traveled further into space? We have. It is not because the technology is lacking – in fact, using the technology we have today it might be possible to achieve these aims (Wall 2013). The main limiting factor is the cost. For instance, the Curiosity mission cost 2.8 billion US dollars. During the mission, a rover was sent to Mars to investigate the composition of the soil. The cost of this was not insanely high, but with a budget for space exploration that keeps being cut by governments of developed countries around the globe (Luxton 2016); it is hard to find the money for longer, manned missions in space. |
Technology news
 | New undersea cable will speed US-Japan connectionAn undersea cable backed by Google and Asian companies aimed at boosting trans-Pacific broadband was put into service on Thursday, the consortium announced. |
 | Car wheels that go in surprising directions could make parking actually fun(Tech Xplore)—Ryan Mandelbaum in Popular Science is just one of a number of tech sites taking a look at wheels that allow the driver to move the car any which way. |
 | VR dream builders at Google work on immersive browsing(Tech Xplore)—How to bring VR to the Web? How to bring the web to VR? Double Hmmm. |
 | Facebook will automatically translate posts into different languagesFacebook on Friday began testing a translation tool that will automatically let posts be displayed in languages users prefer. |
 | Death sparks 'Autopilot' car probe; man had speeding tickets (Update)The first American death involving a car in self-driving mode presents a dilemma: How aggressively to embrace the potentially life-saving technology after a fatal crash. The driver's history of speeding complicates the question. |
 | US man claims Apple owes him a fortune for iPhone ideaA Florida man who claims Apple made a killing with his iPhone idea is suing the technology giant seeking billions of dollars. |
 | Grade-school students teach a robot to help themselves learn geometryComputer technology has become integral to the learning process. According to the National Center for Education Statistics, at the end of the last decade, some 97 percent of U.S. teachers had one or more computers located in the classroom every day, and the ratio of students to computers in the classroom every day was a little over 5 to 1. With the advent of tablet and hand-held computing devices, this ratio is fast approaching 1 to 1. |
UW project highlights liability of internet 'intermediaries' in developing countriesHow much liability do website owners and other online service providers have for content posted by other people? If someone posts content on your website that is defamatory, constitutes hate speech, disseminates child pornography or invades someone's privacy, are you liable? | |
Yahoo CEO paints bright picture with potential sale loomingYahoo CEO Marissa Mayer has tried to paint a bright picture during an annual shareholders meeting as the company considers selling its slumping internet operations. | |
 | Tesla crash could hurt sentiment on driverless carsIt was the crash the auto industry knew was coming but still feared. |
Oracle told to pay HP billions in chip disputeA California jury on Thursday ordered business software giant Oracle to pay Hewlett Packard Enterprise $3.1 billion for backing off a promise to support data servers powered by Itanium chips. | |
Apple considering Tidal music purchase: reportApple is exploring the purchase of rival music streaming service Tidal, which is run by rap star Jay-Z, the Wall Street Journal reported Thursday. | |
 | Personal projects are key to dream job, says Facebook's creative 'rebel'Standing out from the crowd in today's digital economy isn't easy, but the key might be pursuing personal projects more than polishing CVs, according to a senior member of Facebook's creative team. |
Court freezes Facebook's funds in BrazilA Brazilian news site says a federal court has ordered more than $6 million in Facebook funds frozen because its popular messaging service WhatsApp failed to turn over messages sought in a drug case. | |
 | LG Innotek unveils flexible textile pressure sensorsLG Innotek today announced a development of new concept textile flexible pressure sensors. This sensor senses pressure from the entire surface of the sensor and it is even bendable. |
 | Fine-tuning prosthetics for cyclistsDisabled cyclists will be among those competing at the Paralympic Games in Rio de Janeiro in September 2016. Ensuring top performance calls for prosthetics of superior design, but tailoring them to handle the combination of movements cyclists make has always been a problem. Now, in a new movement lab, a test prosthesis is helping to quickly and precisely optimize these artificial limbs. |
 | Better quality control with digital assistance systemsErrors can be spotted early and resources can be saved when many individuals share knowledge in a company. This is the case with a honing machine used to hone crankcases at VW's engine plant in Salzgitter: A digital assistance system developed by Fraunhofer researchers will enable significantly more workers to ensure the quality of honing in the future than now. |
 | Referendum petition hack shows even democracy can be trolledThe electronic petition submitted to parliament calling for a second referendum on Britain's exit from the European Union is a notable development in digital democracy. The number of signatories has passed 4m – how many will be required for it to represent a legitimate form of mass protest that deserves a political response? It's certainly the most significant example of clicktivism the world has ever seen. |
 | Computer models reduce production costsResearchers at the University of Twente are working on computer models that can make industrial production processes significantly more accurate and therefore cheaper. The models help to detect anomalies in the metal forming process at an early stage. Initial simulations with the models have produced promising results. |
 | The flexible, durable solar cellOn a recent warm day in San Diego, Timothy O'Connor wrapped a Band-Aid-sized strip of solar cells around his wrist and walked outside into the sunshine. He plunged his fingers between his wrist and the solar strip and repeatedly twisted and crumpled the solar cells. He repeated the motion 1,000 times. |
 | Miniature flying robots automatically inspect, analyze, and assess damage to infrastructureNext month, the contractor for the Massachusetts Department of Transportation expects to begin Stage 4 of construction on the historic Longfellow Bridge, which connects Boston and Cambridge, its iconic "salt and pepper" towers guiding the passage. But delays to repairing the bridge are legion, as noted in a recent Boston Globe opinion piece. Will it happen? |
New study reveals television newsroom social media practices policies lag behindSocial media is changing the way journalists do their jobs, but policies for television journalists haven't caught up with the practice, increasing the chances that they report false information. That's one result from a study conducted by Anthony Adornato, assistant professor of journalism at Ithaca College. | |
 | In Brexit, London startups see risk—and some opportunitiesWithin 24 hours of Britain's vote to leave the European Union, London-based technology startup Netz saw five investors suspend hundreds of thousands of pounds in promised money. |
 | 3-D paper-based microbial fuel cell operating under continuous flow conditionA team of researchers from the Iowa State University in Ames, IA has demonstrated a proof-of-concept three-dimensional paper-based microbial fuel cell (MFC) that could take advantage of capillary action to guide the liquids through the MFC system and to eliminate the need for external power. Their report appears in the forthcoming issue of the journal Technology. |
 | Fatal Telsa crash shows limits of self-driving technologyThe U.S. government is investigating the first reported death of a driver whose car was in self-driving mode when he crashed. Joshua D. Brown, 40, died May 7 when his Tesla Model S, which was operating on "autopilot," failed to activate its brakes and hit a truck in Florida. |
 | Tesla fatal crash is setback to autonomous carsIt could be a wakeup call for the self-driving car movement. |
 | Google pays its taxes, senior Europe executive insistsGoogle pays taxes in every country where it has a presence, the multinational tech giant's Europe vice president Carlo d'Asaro Biondo said Friday as the company faces a raft of fiscal probes across the continent |
 | How we want to live in 2053As part of the "Shaping Future" research project, Fraunhofer researchers have developed an original participatory foresight methodology with which laymen can describe their future technology requirements and share them with scientists. Initial results show that people want to have technologies that improve their mental and physical capabilities, protect their privacy and store and transport emotions. |
Medicine & Health news
 | Unexpected finding links cell division, glucose, and insulinProteins that play key roles in the timing of cell division also moonlight in regulating blood sugar levels, UT Southwestern Medical Center researchers have found. |
 | Benign bacteria block mosquitoes from transmitting Zika, chikungunya virusesResearchers at the University of Wisconsin-Madison have confirmed that a benign bacterium called Wolbachia pipientis can completely block transmission of Zika virus in Aedes aegypti, the mosquito species responsible for passing the virus to humans. |
New method provides better information on gene expressionScientists at Karolinska Institutet and the Royal Institute of Technology (KTH) have devised a new high-resolution method for studying which genes are active in a tissue. The method can be used on all types of tissue and is valuable to both preclinical research and cancer diagnostics. The results are published in the journal Science. | |
 | Social priming experiment suggests physical magnets can cause people to feel closer to a partner(Medical Xpress)—A team of researchers working at Texas A&M University has found that people playing with physical magnets can come to feel closer to their romantic partner. In their paper posted on the open access site PLOS ONE, the team describes two nearly identical experiments they conducted with volunteers, their results and why they believe they have found an incidence of social priming. |
 | A host of common chemicals endanger child brain development, report saysIn a new report, dozens of scientists, health practitioners and children's health advocates are calling for renewed attention to the growing evidence that many common and widely available chemicals endanger neurodevelopment in fetuses and children of all ages. |
 | Researchers use gelatin instead of the gym to grow stronger musclesUSC researcher Megan L. McCain and colleagues have devised a way to develop bigger, stronger muscle fibers. But instead of popping up on the bicep of a bodybuilder, these muscles grow on a tiny scaffold or "chip" molded from a type of water-logged gel made from gelatin. |
 | Researchers describe copper-induced misfolding of prion proteinsIowa State University researchers have described with single-molecule precision how copper ions cause prion proteins to misfold and seed the misfolding and clumping of nearby prion proteins. |
 | Dividing T cells: A potential target for improving cancer immunotherapyWhen an immune T cell divides into two daughter cells, the activity of an enzyme called mTORC1, which controls protein production, splits unevenly between the progeny, producing two cells with different properties. Such "asymmetric division," uncovered by Johns Hopkins Kimmel Cancer Center researchers using lab-grown cells and specially bred mice, could offer new ways to enhance cancer immunotherapy and may have other implications for studying how stem cells differentiate. |
 | Cerebrovascular disease linked to Alzheimer'sWhile strokes are known to increase risk for dementia, much less is known about diseases of large and small blood vessels in the brain, separate from stroke, and how they relate to dementia. Diseased blood vessels in the brain itself, which commonly is found in elderly people, may contribute more significantly to Alzheimer's disease dementia than was previously believed, according to new study results published in June in The Lancet Neurology, a British medical journal. |
Telomere length is indicator of blood count recovery in treatment of Acute Myeloid LeukemiaThe chemotherapy treatments necessary to treat Acute Myeloid Leukemia (AML) in children can be grueling on the body, and can cause health-related complications during therapy, as well as long down the road after remission. Children receiving chemotherapy for AML receive 4 to 5 intensive chemotherapy courses, and while some children recover quickly from each course, others may take several months or more, which increases their risk for life-threatening infections. | |
 | New technology helps ID aggressive early breast cancerWhen a woman is diagnosed with the earliest stage of breast cancer, how aggressive should her treatment be? Will the non-invasive cancer become invasive? Or is it a slow-growing variety that will likely never be harmful? |
 | Researchers study how cochlear implants affect brain circuitsFour-year-old William Wootton was born profoundly deaf, but thanks to cochlear implants fitted when he was about 18 months old, the Granite Bay preschooler plays with a keyboard synthesizer and reacts to the sounds of airplanes and trains, while still learning American Sign Language. |
Artificial pancreas likely to be available by 2018The artificial pancreas—a device which monitors blood glucose in patients with type 1 diabetes and then automatically adjusts levels of insulin entering the body—is likely to be available by 2018, conclude authors of a paper in Diabetologia (the journal of the European Association for the Study of Diabetes). Issues such as speed of action of the forms of insulin used, reliability, convenience and accuracy of glucose monitors plus cybersecurity to protect devices from hacking, are among the issues that are being addressed. | |
Survey of 15,000 women and men reveals scale of infertilityOne in eight women and one in ten men have experienced infertility, yet nearly half of them have not sought medical help, according to a study of more than 15,000 women and men in Britain published in Human Reproduction, one of the world's leading reproductive medicine journals. | |
 | Aging population is growing ranks of cancer survivorsImproved cancer detection and treatment efforts, combined with demographic trends, are creating larger numbers of older cancer survivors who are likely to have other health conditions that impact care and well-being. |
New anti-cancer strategy mobilizes both innate and adaptive immune responseThough a variety of immunotherapy-based strategies are being used against cancer, they are often hindered by the inability of the immune response to enter the immunosuppressive tumor microenvironment and to effectively mount a response to cancer cells. Now, scientists from the RIKEN Center for Integrative Medical Sciences have developed a new vaccine that involves injecting cells that have been modified so that they can stimulate both an innate immune response and the more specific adaptive response, which allows the body to keep memories and attack new tumor cells as they form. In the study published in Cancer Research, they found that the vaccine made it possible for killer CD8+T-cells—important players in the immune response against cancer—to enter the tumor microenvironment and target cancerous cells. | |
 | Sunscreen doesn't work as well as it says: What to do?Something to consider as you head to the beach or pool over the July Fourth weekend: That sunscreen in your bag may not protect your skin as much as you think. |
 | Natural metabolite can suppress inflammationAn international group of scientists from the U.S., Canada, Germany and Russia has revealed a naturally occurring organic compound that can suppress the pro-inflammatory activity of macrophages. The compound, itaconate, is released in large quantities by macrophages, but until now, its role has been poorly understood. Now, scientists have found evidence that itaconate acts as an antioxidant and anti-inflammatory agent. These properties make itaconate promising for the treatment of pathologies caused by excessive inflammation or oxidative stress. Such conditions may be associated with cardiac ischemia, metabolic disorders and perhaps autoimmune diseases. The findings were published in Cell Metabolism. |
New discovery in connectome dynamicsFrom diffusion tensor imaging data of the Human Connectome Project, it is possible today to construct hundreds of graphs mapping the cerebral connections of a human subject. Each of these graphs has 1015 vertices and several thousand edges. | |
New genetic findings help explain inherited predisposition to myelomaResearchers have identified eight new genetic variations in the human genome that could be linked to an increased risk of developing myeloma. The findings provide additional evidence and build on existing research that suggests myeloma can run in families. | |
 | Explainer: What are women's options for giving birth?For many women, getting pregnant is the easy part. After that line appears on the pregnancy test, it can be difficult to work out who to visit for care, and where you should have your baby. |
 | Early-onset Alzheimer's—should you worry?You have forgotten where you put your car keys, or you can't seem to remember the name of your colleague you saw in the grocery store the other day. You fear the worst, that maybe these are signs of Alzheimer's disease. |
Tracking brain atrophy in MS could become routine, thanks to new softwareThe loss of brain tissue, called brain atrophy, is a normal part of aging, but multiple sclerosis (MS) accelerates the process. Such atrophy is a critical indicator of physical and cognitive decline in MS, yet because measuring brain atrophy is expensive and complicated, it's done primarily in research settings. | |
Calculator can predict psychosis riskAn individual's risk for developing psychosis can be measured as accurately as a prognosis for heart disease and cancer, according to a new Yale-led study published July 1 in the American Journal of Psychiatry. | |
How the 'Biggest Loser' permanently ruins participants' metabolismThe Biggest Loser has received a healthy dose of backlash from the medical community over recent years; all of it well deserved. | |
 | Combination therapy best combats heart diseaseUsing combination drugs or 'polypills', may hold the key to reducing heart disease in Western Australia. |
 | Common over‑the‑counter meds show signs of boosting anti‑cancer immunityDalhousie Medical School researchers are investigating how common over-the-counter drugs used for the treatment of gastrointestinal disorders might enhance the body's immune system and ability to fight off cancer. |
 | Prenatal exposure to paracetamol may increase autism spectrum and hyperactivity symptoms in childrenA new study has found that paracetamol (acetaminophen), which is used extensively during pregnancy, has a strong association with autism spectrum symptoms in boys and for both genders in relation to attention-related and hyperactivity symptoms. |
 | Cravings for high-calorie foods may be switched off in the brain by new supplementEating a type of powdered food supplement, based on a molecule produced by bacteria in the gut, reduces cravings for high-calorie foods such as chocolate, cake and pizza, a new study suggests. |
 | Fair play? How 'smart drugs' are making workplaces more competitiveWe live in an increasingly competitive world where we are always looking to gain an advantage over our rivals, sometimes even our own colleagues. In some cases, it can push people to extreme, unethical and illegitimate methods – something we've seen recently in the doping scandal that has hit the athletics world. |
 | How brain implants can let paralysed people move againSomething as simple as picking up a cup of tea requires an awful lot of action from your body. Your arm muscles fire to move your arm towards the cup. Your finger muscles fire to open your hand then bend your fingers around the handle. Your shoulder muscles keep your arm from popping out of your shoulder and your core muscles make sure you don't tip over because of the extra weight of the cup. All these muscles have to fire in a precise and coordinated manner, and yet your only conscious effort is the thought: "I know: tea!" |
Consensus statement: Environmental toxins hurt brain development, action neededAn unprecedented alliance of leading scientists, medical experts, and children's health advocates argue that today's scientific evidence supports a link between exposures to toxic chemicals in air, food, and everyday products and children's risks for neurodevelopmental disorders. The alliance, known as Project TENDR, which stands for "Targeting Environmental Neuro-Developmental Risks," is calling for immediate action to significantly reduce exposures to toxic chemicals to protect brain development. | |
 | Electronic tablets speed stroke care during patient transport, study findsA clinical trial testing mobile videoconferencing as a means for physicians to diagnose stroke patients while they're being transported to the hospital has found that a tablet-based system produced diagnoses highly correlating with a bedside assessment—a finding that could have important implications for the early treatment of stroke and for preventing the disability it causes. |
 | Are we giving up on cardiac arrest patients too soon?Physicians may be drawing conclusions too soon about survival outcomes of patients who suffered a cardiac arrest outside the hospital. |
 | Blood coagulation detector may help in monitoring stroke riskAtrial fibrillation (AF) causes an irregular and sometimes fast heart rate, and is a common risk factor for stroke. To estimate this risk in AF patients and determine the requirement for anticoagulation therapy, the CHADS2 predictive score is used. Because some parts of this score are also associated with atherosclerosis risk and increased blood coagulability, a high score has been proposed as linked to hypercoagulability (an increased tendency for blood clotting) in both AF and non-AF patients. However, this association has not been fully investigated, partly owing to the lack of a sensitive means of detection. |
 | Key difference in immune cells may explain children's increased susceptibility to illnessSchools are commonly known as breeding grounds for viruses and bacteria, but this may not necessarily be linked to hygiene. New research in mice shows that because their immune systems do not operate at the same efficiency as adults, children may not only be more likely to contract a viral infection, but they also take to longer clear it. Specifically, the study examined how CD4 T-cells (immune cells that play a key role in fighting viral infections) respond to influenza, and found that children's immune systems may not yet be able to make enough antibody molecules to rid their lungs of the influenza virus as quickly as adults. These findings were reported in the July 2016 issue of the Journal of Leukocyte Biology. |
 | Traffic deaths surged in 2015 as driving hit new recordTraffic deaths surged last year as drivers racked up more miles behind the wheel than ever before, a result of an improved economy and lower gas prices, according to preliminary government data released Friday. |
 | FDA approves new test to help detect drug-resistant bacteria(HealthDay)—The Xpert Carba-R Assay diagnostic, which tests patient specimens for genetic markers associated with drug-resistant bacteria, has been approved by the U.S. Food and Drug Administration. |
 | FDA approves eye implant to correct presbyopia in middle age(HealthDay)—An implant that helps the aging eye focus on small print and nearby objects has been approved by the U.S. Food and Drug Administration. |
 | When cooking outside, don't let food safety slide(HealthDay)—Food is a big part of many Fourth of July celebrations. But take care when making and storing your meal, so that a bout of food poisoning doesn't ruin the rest of your holiday plans, a dietary expert advises. |
 | Handle fireworks with care on the fourth(HealthDay)—Americans love fireworks, especially on the Fourth of July, but experts warn they can be dangerous if not used safely. |
 | The relentless dynamism of the adult brainScientists from the Institut Pasteur and the CNRS were able to make real-time observations over a period of several months that reveal how new adult-born neurons are formed and evolve in the olfactory bulb of mice. They made the surprising discovery that there is constant structural plasticity in the connections established by these new neurons with the circuits into which they are recruited. The scientists showed that this neuronal dynamism can enable optimal processing of sensory information by the olfactory bulb. These findings are to be published in the journal Neuron on June 30, 2016. |
 | Zika virus research aims to control, fight mosquitoesKansas State University is helping the fight against Zika virus through mosquito research. |
 | Walking meetings could bring longer and healthier lives to office workersChanging just one seated meeting per week at work into a walking meeting increased the work-related physical activity levels of white-collar workers by 10 minutes, according to a new study published by public health researchers with the University of Miami Miller School of Medicine. The study, published June 24, 2016 in the Centers for Disease Control and Prevention's journal Preventing Chronic Disease, suggests a possible new health promotion approach to improving the health of millions of white-collar workers who spend most of their workdays sitting in chairs. |
CDC: Amoeba didn't die in whitewater center's murky churnThe chlorination and filtration systems at an artificial water rapids course where Olympic kayakers train were inadequate to kill a rare, brain-attacking organism, the U.S. Centers for Disease Control and Prevention said after an Ohio teenager died from the amoeba. | |
 | Fludrocortisone linked to reduction in vasovagal syncope(HealthDay)—Fludrocortisone is associated with a reduction in the risk of vasovagal syncope, according to a study published in the July 5 issue of the Journal of the American College of Cardiology. |
 | Invasive prenatal testing doesn't up HIV transmission risk(HealthDay)—For pregnant women with HIV infection, invasive prenatal testing does not increase the risk of vertical transmission, according to a study published online June 20 in BJOG: An International Journal of Obstetrics & Gynaecology. |
 | Zeaxanthin-based supplement improves skin hydration(HealthDay)—For females, a zeaxanthin-based dietary supplement and topical serum (with zeaxanthin, algae extracts, peptides, and hyaluronate) improve hydration and reduce wrinkle count, according to a study published online June 17 in the Journal of Cosmetic Dermatology. |
 | Extended-spectrum antibiotics no benefit for pediatric appendicitis(HealthDay)—For children diagnosed with appendicitis undergoing appendectomy, extended-spectrum antibiotics seem to offer no advantage over narrower-spectrum agents, according to a study published online June 28 in Pediatrics. |
 | Family key to helping teens avoid obesity(HealthDay)—Having a stable family and a good relationship with mom and dad makes young people more likely to develop healthy habits that may protect them against obesity, a new study suggests. |
 | Glucagon-like peptide-1 receptor agonists beneficial as add-on(HealthDay)—Lixisenatide and glulisine as add-on to basal insulin result in a reduction in glycated hemoglobin (HbA1c) levels in patients with type 2 diabetes, according to a study published online June 22 in Diabetes Care. |
 | About 1.6M drop-outs from health law coverage this yearAbout 1.6 million people who signed up for coverage this year under President Barack Obama's health care law dropped out by the end of March, according to administration figures released late Thursday. |
This week in BMJ Case Reports: Infection from pet dog, pinworms, Indian herbal remedyWoman admitted to intensive care after infection from pet dog | |
US needs greater preparation for next severe public health threats, panel findsIn a report released today by the U.S. Department of Health and Human Services (HHS), an Independent Panel formed to review HHS's response to Ebola made several recommendations on how the nation's federal public health system should strengthen its response to major public health threats, both internationally and domestically. | |
Report highlights cost estimates for training residents in a Teaching Health CenterA new study reveals that the average cost to train a Teaching Health Center resident is estimated to be $157,602 per year. The report, "The Cost of Residency Training in Teaching Health Centers", published by the New England Journal of Medicine comes as current Teaching Health Centers embark on what could be their last year in existence starting July 1, 2016. | |
UK government should fund media campaigns that promote quitting, not films that promote smokingA letter from leading international tobacco researchers published today by Addiction calls for the UK government to stop subsidising films that they claim promote smoking and spend more on media campaigns that promote quitting. | |
 | Uncertainty looms as Vermont becomes 1st state to label GMOsAt Mehuron's Supermarket in Waitsfield, manager Bruce Hyde Jr. said he and his team were ready for the state's new law requiring genetically modified foods to be labeled as such. But uncertainties abound. |
Federal judge blocks new Florida abortion lawA federal judge late Thursday put on hold key portions of a new Florida law that would block public funding for Planned Parenthood and greatly increase inspection requirements for abortion clinics. | |
 | Texas abortions fell sharply under law Supreme Court voidedAbortions in Texas plummeted about 15 percent during the first year after approval of tough restrictions that the U.S. Supreme Court has since struck down—a decline that activists say shows how hard it had become to get an abortion in America's second-largest state. |
 | New insights for personalized cancer treatmentDoctors increasingly work with large quantities of digitized patient data – and yet the insights it contains often remain unexploited. Fraunhofer researchers have developed a software program that allows doctors to extract information from multiple patient files to quickly obtain new pointers for the treatment of prostate cancer. |
 | New food labels show appetite for changeNew federal government country of origin food labels are a good start, but there is plenty of scope to go even further according to a University of Queensland researcher. |
Time to remove barriers that stop girls being more activeAdolescent girls are missing out on opportunities to be as physically active as boys and a Melbourne researcher says that schools and sporting clubs are the place to start to change this inequity. | |
 | African ancestry and dangerous blood clotsInappropriate blood clotting can be a killer. Each year in the US, 300,000 to 900,000 people suffer a venous thromboembolism (VTE), which includes deep vein thrombosis (DVT) and pulmonary embolism (PE). African Americans have a 30–60% higher incidence of either or both than people of European ancestry. |
 | Gene-based agents for the treatment of congenital eye diseasesPharmacologists at LMU have developed gene-based agents for the treatment of congenital eye diseases. The first of these is now undergoing a phase-I clinical trial in color-blind patients at the University Medical Center in Tübingen. |
Googling 'liposuction'? Study shows low quality of online informationPatients doing Internet searches to learn about liposuction will find overall "very poor" quality of information, reports a study in Plastic and Reconstructive Surgery—Global Open, the official open-access medical journal of the American Society of Plastic Surgeons (ASPS). | |
Routine eye exams lead to high rate of change in vision status or careDo you really need to get your eyes checked—even if you haven't noticed any vision problems or eye-related symptoms? More than half of routine eye examinations in asymptomatic patients lead to a change in vision prescription or other changes in care, according to a study in the June issue of Optometry and Vision Science, official journal of the American Academy of Optometry. | |
General Mills expands flour recall after outbreak of E. coliGeneral Mills is expanding its recall of certain types of flour in response to an ongoing outbreak of illnesses related to a strain of E. coli bacteria. | |
Biology news
 | Climate change's effect on Rocky Mountain plant is driven by sexFor the valerian plant, higher elevations in the Colorado Rocky Mountains are becoming much more co-ed. And the primary reason appears to be climate change. |
 | E. coli: The ideal transport for next-gen vaccines?Most people recoil at the thought of ingesting E. coli. But what if the headline-grabbing bacteria could be used to fight disease? |
| Gene amplification – the fast track to infectionResearchers at Umeå University are first to discover that bacteria can multiply disease-inducing genes which are needed to rapidly cause infection. The results were published in Science on 30 June 2016. |
Analysis of anatomy and diet finds evolution follows least resistant pathEvolution follows the path of least resistance, which can result in suboptimal physical traits that don't ideally match the functional need, according to a new analysis by University of Arkansas anthropologist Peter Ungar. | |
 | Ancient symbiosis points to possible whitefly controlsUncovering the details of a 100 million-year-old symbiosis between bacteria and whiteflies opens the door for controlling an insect pest that is rated one of the top 10 invasive species on the planet. |
 | Great frigate birds found able to fly for months at a time(Phys.org)—A small team of researchers with members from France, the U.K., Canada and Germany has discovered that the great frigate bird (Fregata minor) is able to stay aloft for up to two months at a time. In their paper published in the journal Science, the team describes how they affixed trackers to several of the birds as part of a two-year study, what they found, and even offer some ideas on how the birds manage to sleep. Raymond Huey and Curtis Deutsch, with the University of Washington in Washington State, offer a Perspective piece on the work done by the team in the same journal issue. |
 | Individual mycobacteria respond differently to antibiotics based on growth and timingTuberculosis is one of the most common infectious diseases in the world, infecting almost 10 million people each year. Treating the disease can be challenging and requires a combination of multiple antibiotics delivered over several months. This is due, in part, to variations in antibiotic tolerance among subpopulations of Mycobacterium tuberculosis, the bacteria that cause tuberculosis. |
El Nino brings sharks, other marine life to California coastShark encounters and sightings along California's coast are at their highest level in decades, scientists say, warning that warmer waters mean beachgoers will have to be on the lookout for the predators all summer. | |
 | New survey seeks to understand how good UK gardens are for pollinatorsThe Royal Horticultural Society (RHS) and the University of Bristol are asking gardeners to take part in a new study to identify the most commonly planted pollinator-friendly plants and assess how good UK gardens are for pollinators. |
 | Beetles are coming to eat all our trees: Their eyes may be the key to stopping themThe Emerald Ash Borer is eating its way across America. Next stop? Utah. |
 | Decoding the complete genome of the Mediterranean's most emblematic tree—the oliveThe olive was one of the first trees to be domesticated in the history of mankind, probably some 6,000 years ago. A Mediterranean emblem par excellence, it is of vital importance to the Spanish and other regional economies (Italy, Greece and Portugal). In fact, Spain is the leading producer of olive oil in the world. Every year, nearly three million tons of oil are produced, for local consumption and export. Spain produces one third of this total. |
 | The discovery of a totally new kind of 'mark' in human cell nucleusJapanese research group verified the presence of a protein modification that is a unique mark in human cell nucleus. This protein modification, Histone H4 lysine 20 acetylation (H4K20ac), was only discovered in plant cells and its existence in mammalian cells has been indirectly proven. Their study suggests that H4K20ac is associated with gene repression. This new discovery of H4K20ac may lead to further clarification of the mechanisms in disease progression. |
 | Geomicrobiologists show that many bacteria and fungi in soil make organohalogensOrganohalogens like perchloroethene and trichloroethene are prominent groundwater pollutants due to their industrial use as dry cleaning and degreasing agents and their widespread release into the environment. Volatile organohalogens like chloromethane strongly influence atmospheric chemistry and thereby Earth's climate by causing ozone depletion when released into the atmosphere. For a long time it was assumed that these compounds are only produced and released by human activity. However, in recent years, over 5,000 naturally-occurring organohalogen compounds have been identified, and evidence suggests that the cycling of halogens e.g. chlorine, bromine in soils is largely driven by microbial processes. |
 | How researchers use genomics to predict bread quality and accelerate wheat variety developmentA team of breeders and geneticists at Kansas State University and the International Maize and Wheat Improvement Center, or CIMMYT, has come up with a new approach to determine if new varieties of bread wheat will have what it takes to make better bread. |
 | Scientists hope new shark cam gives insight to deep divesResearchers are developing a one-of-a-kind camera to mount on great white sharks in an effort to discover why the fish travel each year to a spot in the Pacific Ocean nicknamed the "White Shark Cafe." |
 | Park Service uses 'CSI' tactics in response to bear attacksIn what amounts to an innocence project for bears, National Park Service rangers are turning to modern forensic technology, including DNA evidence, to make sure they don't kill the wrong bear when a human is attacked in the mountains. |
 | Bald eagles making strong recovery in VirginiaVirginia's bald eagle population is thriving at levels not likely seen since before the United States was a country, one of the nation's top eagle experts said Friday. |
 | El Nino brings sharks, other marine life to California coastShark encounters and sightings along California's coast are at their highest level in decades, scientists say, warning that warmer waters mean beachgoers will have to be on the lookout for the predators all summer. |
New app lets users track sharks and report sightingsA Massachusetts nonprofit is launching a new smartphone application so beachgoers along the East Coast can report their own shark sightings. | |
 | In hot water: Climate change is affecting North American fishClimate change is already affecting inland fish across North America—including some fish that are popular with anglers. Scientists are seeing a variety of changes in how inland fish reproduce, grow and where they can live, according to four new studies published today in a special issue of Fisheries magazine. |
 | Sri Lanka's latest status symbol, a baby elephantExpensive and high-maintenance, baby elephants have become the ultimate status symbol for Sri Lanka's wealthy elite—a trend that has horrified conservationists and prompted a government crackdown. |
 | Better understanding could lead to more cost-effective production of cellulosic biofuelsPlant cell walls, which constitute the bulk of plant biomass, are diverse, complex, and dynamic in their structural composition and integrity. Cell walls are innately resistant to deconstruction by biological or chemical catalysts. This property is often referred to as recalcitrance, and recalcitrance is considered the primary barrier to cost-effective production of cellulosic biofuels. Pretreatment of plant biomass can loosen the structural integrity of cell walls, reducing their recalcitrance to deconstruction, and this study provides insights into how pretreatment induces such cell wall modifications in different types of biomass. |
 | E. coli fatty acid biosynthesis system could more efficiently convert biomass to desired productsValuable chemicals and fuels have been produced in engineered strains of Escherichia coli by deregulating this organism's fatty acid synthase (FAS), causing the microorganism to pump out chemicals. For example, E. coli produces chemicals used to manufacture detergents and lubricants as well as methyl ketones that have promising fuel properties. Previous microbial production methods have been based on highly regulated enzymatic processes that can limit yield. Researchers developed an alternative FAS system in which enzymes from other organisms work with the native FAS in E. coli to improve the microbe's capacity for chemical production. |
 | Ionic liquids from biomass waste could pretreat plants destined for biofuelsIonic liquids (ILs) have been shown to be an excellent pretreatment solvent for biomass; the ILs prepare the plant matter to be broken down into its component sugars, which can be used in creating biofuels. However, the availability and high cost of petroleum-derived ILs pose challenges. Synthesizing new ILs directly from biomass "wastes" – the lignin monomers and hemicellulose – is being studied as a new approach. |
 | Characterization of poplar budbreak gene enhances understanding of spring regrowthTrees in temperate climates undergo annual cycles of growth and dormancy corresponding to summer and winter seasons, a critical strategy that allows perennial plants to survive cold and dehydration during the winter months. These important transitions are controlled by the length of the day, or photoperiod, and temperature, but the exact mechanisms by which these annual cycles are initiated in the trees are still poorly understood. |
 | Genetic approaches will aid development of higher biomass-yielding, sustainable trees for bioenergy feedstocksLarge, fast-growing poplar trees and other woody plants are desirable starting points, or feedstocks, for producing transportation fuels. The challenge is that the wood-forming materials resist chemical breakdown. Overcoming this recalcitrance is a main goal in bioenergy feedstocks research. Scientists took on this challenge by examining how gene regulatory networks control a plant's resistance to breakdown. They developed two new methods to understand the recalcitrance of woody material. |
 | 'Undead' genes come alive days after deathResearchers from the University of Washington, Seattle, have discovered that genes in animals remain 'turned on' days after death, possibly opening the door to new and better ways for preserving donated organs for transplantation and more accurate methods of determining when murder victims were killed. |
 | Dead whale stuck on Los Angeles beach ahead of holidayA dead humpback whale was stuck on a popular Los Angeles-area beach as the Fourth of July weekend got underway Friday, with visitors urged to steer clear of the huge carcass. |
This email is a free service of Science X Network
You received this email because you subscribed to our list.
If you no longer want to receive this email use the link below to unsubscribe.
https://sciencex.com/profile/nwletter/
You are subscribed as jmabs1@gmail.com
No comments:
Post a Comment